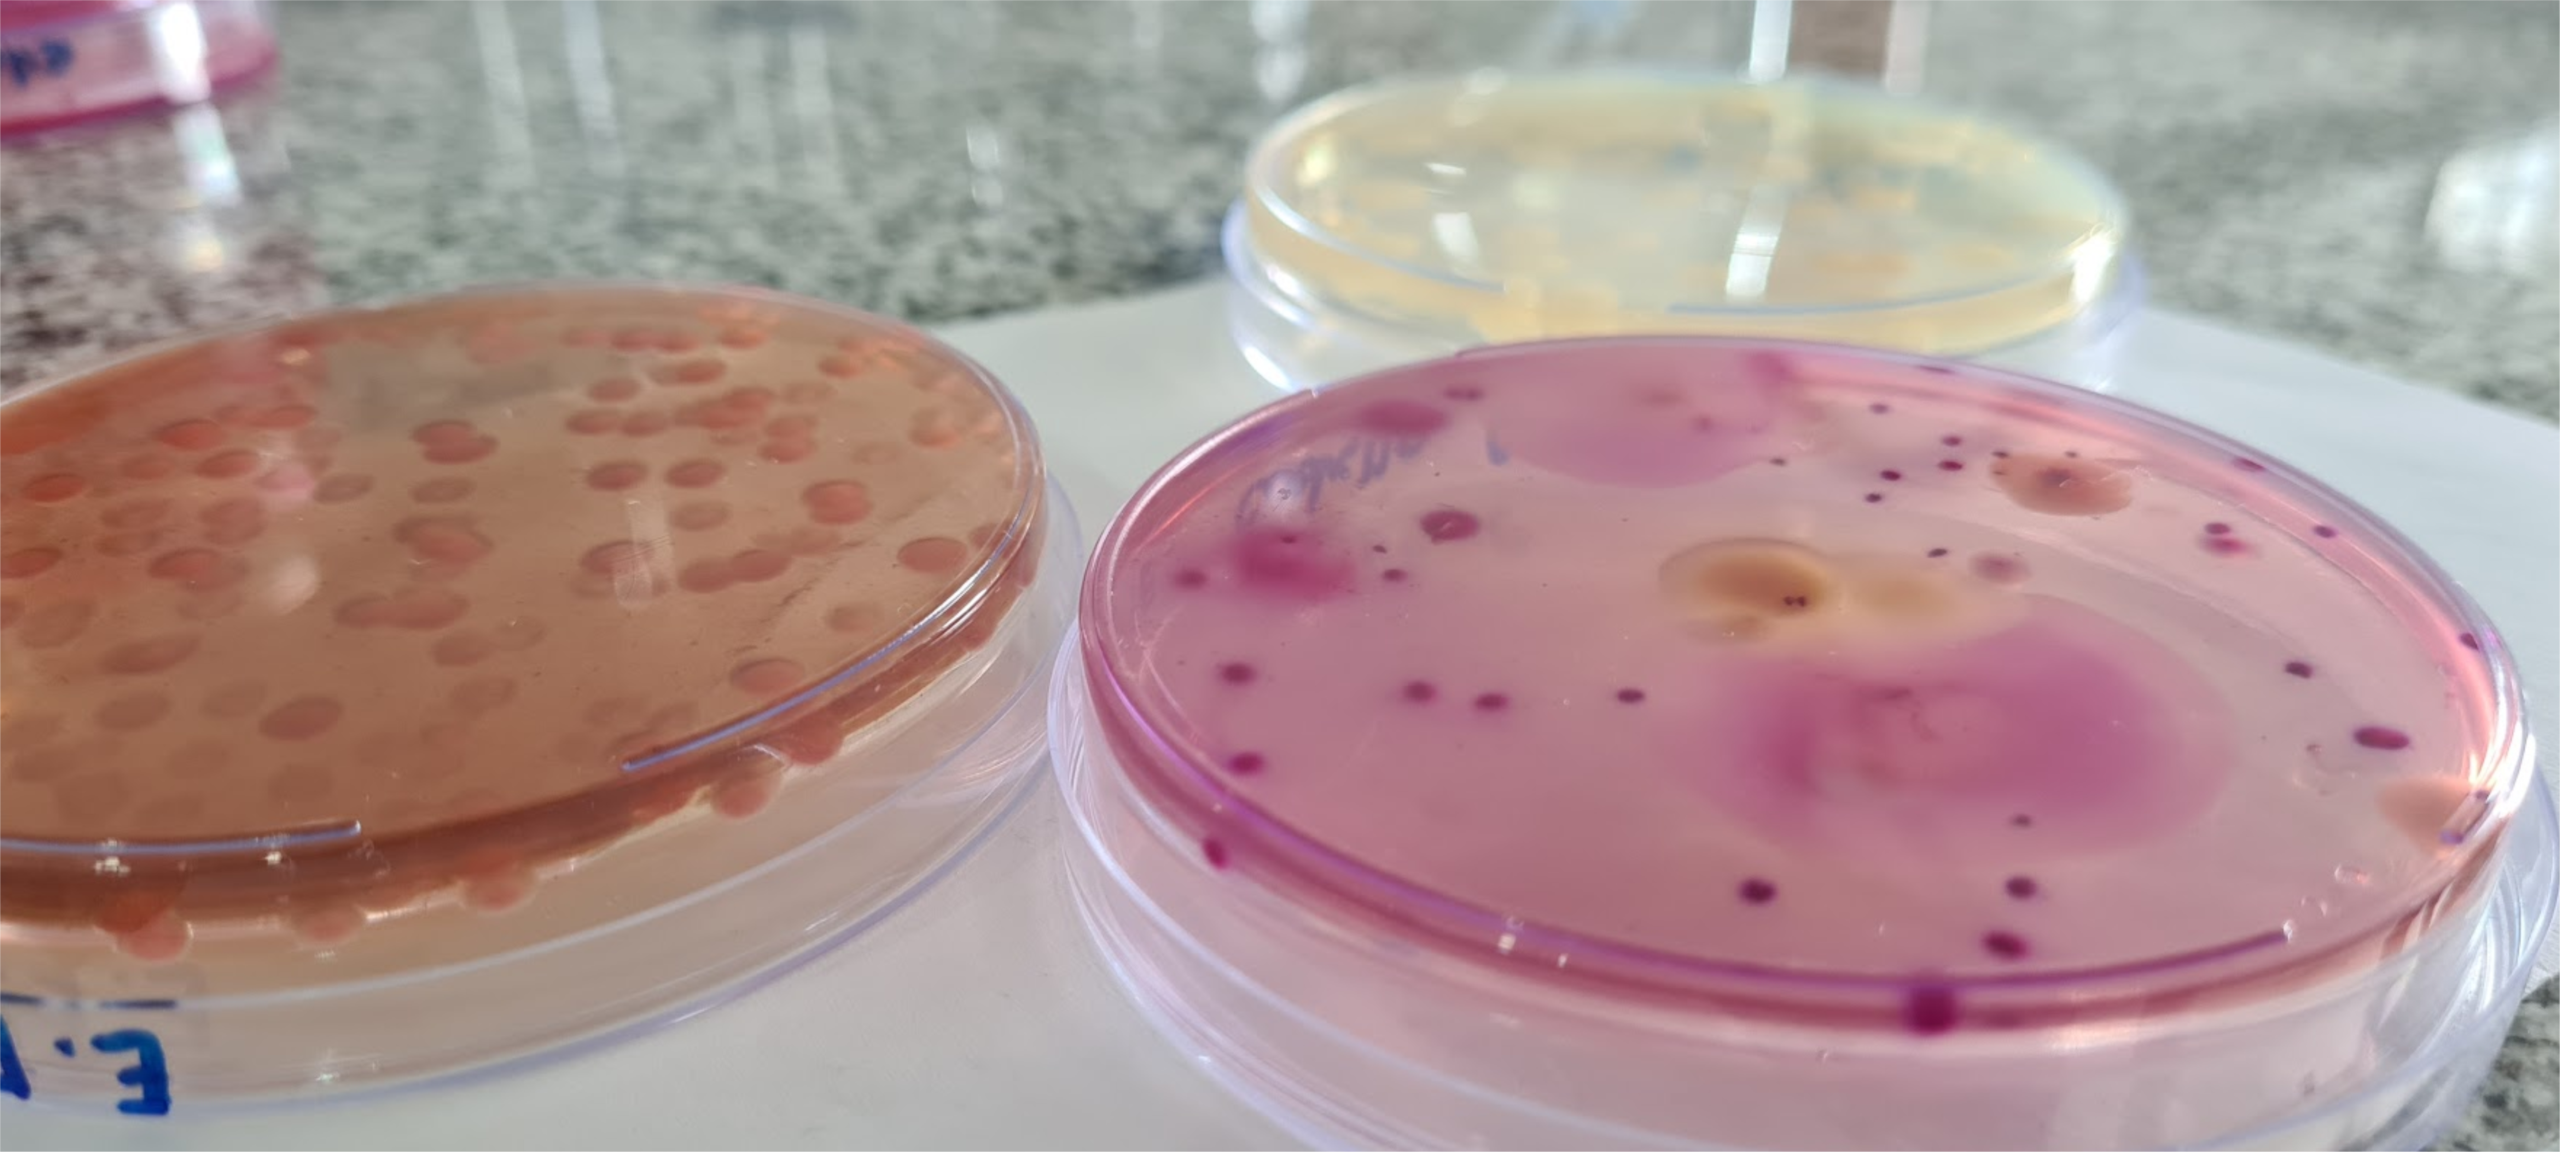

Brindamos soluciones ambientales
Acompañamos cada proyecto de inversión (en todas sus etapas) cuantificando su huella ambiental.

Agua
Caracterización de agua para consumo, riego y recreación.
Aguas superficiales y subterráneas, para uso agrícola, ganadero, industrial, minero, etc.

Efluentes
Muestreo, caracterización y análisis físico-químico y microbiológico de aguas residuales y vertidos industriales.
Control de eficiencia de plantas de tratamiento de efluentes.

Fertilizantes
Análisis físico-químico de aguas de dilución. Caracterización físico-química y traza de elementos.

Hojas
Análisis de nitrógeno foliar, para optimizar el rendimiento de los cultivos, prevenir problemas nutricionales y mejorar la eficiencia de la fertilización.

Alimentos y superficies
Análisis de agua, alimentos, superficies vivas y superficies inertes.

Contamos con laboratorio propio en Salta Capital, con profesionales y analistas salteños.
Nos caracteriza un procesado rápido de las muestras, que nos permite realizar una comunicación con carácter inmediato de los resultados.
Realizamos el servicio completo desde la toma de muestra.
Procesos analíticos automatizados y eficientes.







Nuestros clientes
Envianos tu consulta